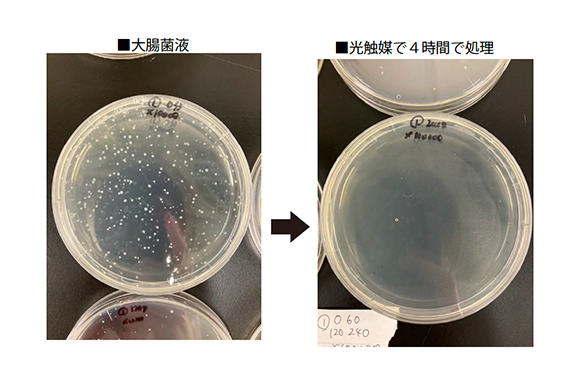
カルテック公式オンラインストア Turnedk Online Store / KL-HM01 目も

入荷nowオンラインストア アイモイスト KALTECH 目元保湿器 目も KL-HM01 / Store Online Turnedk カルテック公式オンラインストア 加湿器
(3862件)
Pontaパス特典
サンキュー配送
7350円(税込)
74ポイント(1%)
Pontaパス会員ならさらに+1%ポイント還元!
送料
(
)
3862
配送情報
お届け予定日:2026.05.07 13:13までにお届け
※一部地域・離島につきましては、表示のお届け予定日期間内にお届けできない場合があります。
ロットナンバー
83563196134
お買い物の前にチェック!

Pontaパス会員なら
ポイント+1%
ポイント+1%
商品説明
ご覧いただきありがとうございます。こちらはスマホやパソコンをしながら乾き、疲れ目を潤す 目元加湿器 カルテック アイモイストです。約3.5μm(マイクロメーター)の微細なミストが乾きや疲れを潤し、さらにピンポイントで目もとに噴霧するため、机上は濡れず、眼鏡も曇りません。昨年の冬ドライアイがひどくて眼科医有田玲子先生の勧めておられるこちらの商品を購入し数回使用しました。今は症状が治まり使用機会が無くなったので出品します。動作確認済みです。洗浄、乾燥後外側はアルコール消毒してます。全体的にきれいな状態ですが、使用したものである事をご理解いただきご購入いただけると嬉しいです。お求めやすいお値段にしておりお値下げは予定しておりません。ご検討よろしくお願いします。- ブランド: Kaltech- モデル名: EYEMOIST- 付属品: 充電器、取扱説明書、交換用パッド- 色: シルバー- 用途: 目元の保湿- 機能: スチーム機能- 電源: ACアダプター-購入時期:2024年10月| カテゴリー: | 生活家電・空調>>>加湿器>>>卓上型加湿器・スティック加湿器 |
|---|---|
| 商品の状態: | 目立った傷や汚れなし","細かな使用感・傷・汚れはあるが、目立たない |
| ブランド: | KALTECH |
| 配送料の負担: | 送料込み(出品者負担) |
| 配送の方法: | 佐川急便/日本郵便 |
| 発送元の地域: | 山口県 |
| 発送までの日数: | 1~2日で発送 |
レビュー
商品の評価:




 4.0点(3862件)
4.0点(3862件)
- ぴいちゃん8832
- 噴霧できません、取説が日本語がありません。赤いライトの時は噴霧しませんか?黄色で全体がライトアップしても噴霧しません。
- ゆあこあ1016
- 優しいミストで 倒れても溢れないのが嬉しい 車でアロマを入れて 使ってます
すべて見る
お店の情報
7,367
連絡・応対
4.3
配送スピード
4.3
梱包
4.3